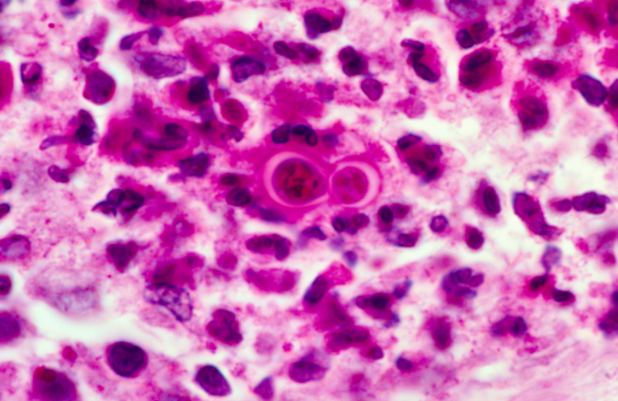

What fungi can cause systemic mycoses?
Histoplasmosis
Blastomycosis
Coccidioidomycosis
Paracoccidioidomycosis
Notes about the systemic mycoses inducing fungi
Tx with fluconazole or itra for local infection and ampho B for systemic
Systemic mycoses can mimic TB (granuloma formation) but…
they have no person-person transmission
What is this?

Histoplasmosis (histo bodies within macrophages)- associated with brid or bat droppings
Where is Histoplasmosis endemic?
Mississippi and Ohio River Valleys- causes pneumonia
Blastomycosis-broad-based buding (same size as RBCs)
Blastomycosis- causes inflammatory lung disease and can disseminate to skin and bone (forms granulomatous nodules)

Blastomycosis- common in states east of the Mississippi River and Central America

Coccidioidomycosis- spherules (much larger than RBCs)- filled with endospores

Coccidioidomycosis

Where is Coccidioidomycosis common?
Southwestern US, California- causes meningitis and penumonia and can disseminate to bone and skin
Common after earthquakes when spores are thrown into the air and inhaled to form spherules

Paracoccidioidoycosis- budding yeast with ‘captains wheel’ formation

Paracoccidioidoycosis-common in Latin America

What are the major cutaneous mycoses?
TInea (dermatophytes)- capitis, corporis, cruris, pedis, unguium
Tinea versicolor
Dermatophytes (tinea) include what spp?
Microsporum
Trichophyton
Epidermophyton
How is Tinea diagnosed?
branching septate hyphae visible on KOH prep with blue fungal stain

How does tinea capitis present?
Occurs on head, scalp, and is associated with LD< alopcia, and scaling

How does tinea corporis present?
Occurs on the body and is marked by erythematous scaling rings (ringworm) and central clearing- can be acquired from contact with an infected dog or cat

How does tinea cruris present?
Occurs in inguinal area and often DOES NOT show the central clearing seen in tinea corporis

Describe tinea pedia
3 varieties:
Interdigital (most common) (below)
Moccasin distribution
Vesicular types

Tinea pedis- Vesicular type

Tinea pedis- Moccasin type

Describe Tinea unguium
Onchomycosis; occurs on nails

What causes Tinea versicolor?
Malassezia spp (Pityrosporum spp.), a yeast-like fungus (not a dermatophyte despite being called tinea)
NOTE: Below: degradation of lipids produces acids that daage melanocytes and cause hypopigmentation and/or pink patches

When is Tinea versicolor most common?
summer (hot, humid weather)
What does Tinea versicolor look like on microscopy?
Spaghetti and meatballs

What are the main opportunistic fungal infections?
Candida albicans
Aspergillus fumigatus
Crytpococcus neoformans
Mucor and Rhizopus spp.
What is this?

Candida albicans- pseudohyphae and budding yeasts at 20C and germ tubes at 37C